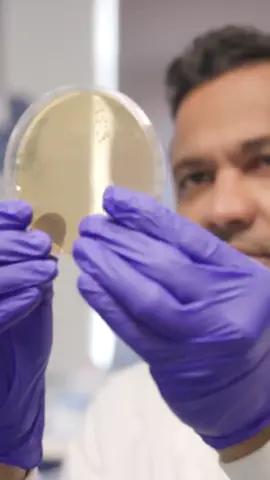
Could gut microbes protect us from toxic 'forever chemicals’? 🧪 Cambridge scientists have discovered that certain species of microbe found in the human gut can absorb PFAS – the toxic and long-lasting ‘forever chemicals.’ They say boosting these species in our gut microbiome could help protect us from the harmful effects of PFAS. #ForeverChemicals #PFAS #CambridgeUniversity #UniversityOfCambridge #Cambridge #Science #Microbiome #GutHealth

Lucky
Region: US
Saturday 01 November 2025 21:02:41 GMT
603
15
10
1
Music
Download
Comments
Gtbushman9 :
either i get rich or die trying
2025-11-01 22:40:21
7
Shut Scientist94 :
win wim
2025-11-01 21:13:18
0
Daniel 🙄 :
Either way I win
2025-11-02 00:11:04
0
JoJo’s Anime :
I see that as a win-win 🙏🏽
2025-11-01 23:19:31
1
Naviw0lf :
2025-11-01 23:10:55
1
dizzyFiz :
Either I’m rich or I don’t need to be rich is this really a question?
2025-11-01 22:24:33
1
Keys :
Maybe 5 bil but shit 5 mil is nothing 😂
2025-11-01 23:06:15
0
Daniel Roman :
Hand me the dice
2025-11-01 23:32:06
0
To see more videos from user @eflores3600, please go to the Tikwm
homepage.